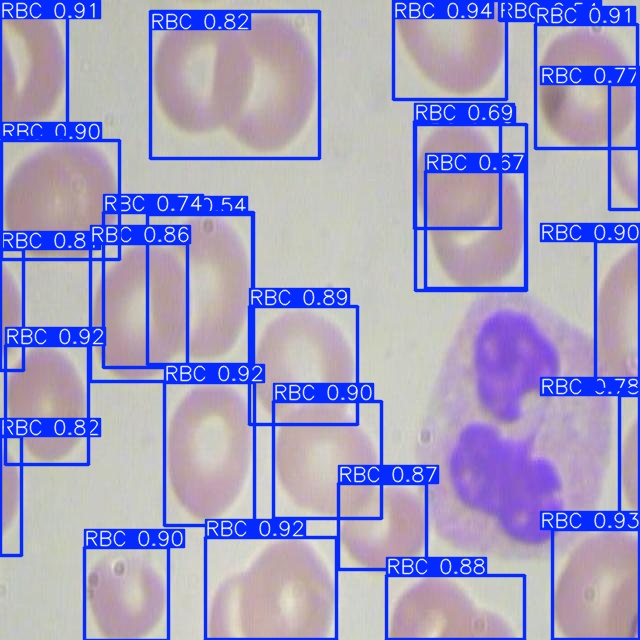

Технологий искусственного интеллекта для анализа биомедицинских изображений
MEVIT — команда, которая органично объединяет медицину и искусственный интеллект, чтобы по-новому взглянуть на медицинские анализы.

Страсть к исследования
Мы занимаемся разработкой и исследованиями в области автоматизации анализа биомедицинских изображений.
Анализ размеров частиц

Агрегация клеток крови

Анализ фаций плазмы крови

Умный микроскоп на базе Искусственного Интеллекта
Мы создали комплексное решение, способное на многое
Программно-аппаратный комплекс
- Автоматизированный столик.
- Адаптивное освещение.
- Компьютерное зрение.
- 120-1200х приближение.
- Низкая стоимость.

Высокая эффективность
- В 300* раз быстрее человека.
- Точность mAP@0.5 до 95.5%**.
- Запуск на одноплатном RISC-V компьютере в реальном времени.
Аддитивные технологии
- Самостоятельно разработанный дизайн.
- Производство деталей на 3D — принтере.
- Адаптация под любые сценарии.

«Per aspera ad astra.»
Смотрите, читайте, слушайте
Присоединяйтесь к 100+ подписчикам
Оставайтесь в курсе всего, что вам нужно знать.
